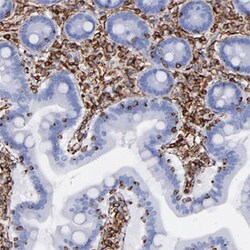

Learn More
VIM Rabbit anti-Human, Mouse, Polyclonal , Abnova™
Rabbit polyclonal antibody raised against recombinant human VIM.
Supplier: Abnova Corporation PAB29375
Description
This gene encodes a member of the intermediate filament family. Intermediate filamentents, along with microtubules and actin microfilaments, make up the cytoskeleton. The protein encoded by this gene is responsible for maintaining cell shape, integrity of the cytoplasm, and stabilizing cytoskeletal interactions. It is also involved in the immune response, and controls the transport of low-density lipoprotein (LDL)-derived cholesterol from a lysosome to the site of esterification. It functions as an organizer of a number of critical proteins involved in attachment, migration, and cell signaling. Mutations in this gene causes a dominant, pulverulent cataract
Sequence: FANYIDKVRFLEQQNKILLAELEQLKGQGKSRLGDLYEEEMRELRRQVDQLTNDKARVEVERDNLAEDIMRLREKLQEEMLQREEAENTLQSFRQDVDNASLARLDLERKVESSpecifications
| VIM | |
| Polyclonal | |
| Rabbit polyclonal antibody raised against recombinant human VIM. | |
| In PBS, pH 7.2 (40% glycerol, 0.02% sodium azide) | |
| VIM | |
| Recombinant protein corresponding to human VIM. | |
| 100 μL | |
| Primary | |
| Human, Mouse | |
| Liquid |
| Immunofluorescence, Immunohistochemistry (PFA fixed), Western Blot | |
| Unconjugated | |
| Immunohistochemistry (1:1000-1:2500) Immunofluorescence (1-4 ug/mL) Western Blot (1:100-1:250) The optimal working dilution should be determined by the end user. | |
| FLJ36605 | |
| Rabbit | |
| Antigen affinity purification | |
| RUO | |
| 7431 | |
| Store at 4°C. For long term storage store at -20°C. Aliquot to avoid repeated freezing and thawing. |
|
| IgG |
Your input is important to us. Please complete this form to provide feedback related to the content on this product.